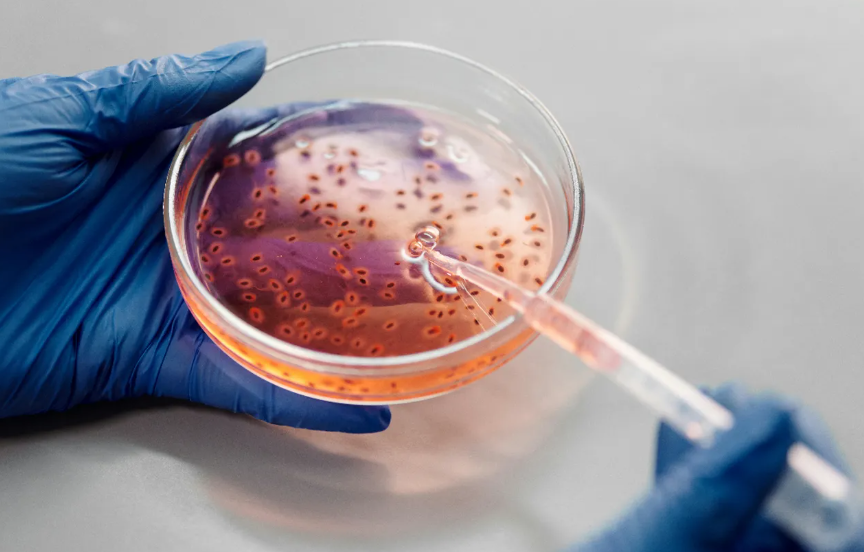

DSÖ’nün Küresel Antimikrobiyal Direnç ve Kullanım Gözetim Sistemi (GLASS) tarafından hazırlanan son rapora göre, 2018-2023 yılları arasında patojen-antibiyotik çiftlerinin yüzde 40’tan fazlasında direnç artışı gözlemlendi. Bu veriler, antibiyotik direncinin artık nadir görülen bir sağlık sorunu olmaktan çıktığını ortaya koyuyor.
ANTİBİYOTİK DİRENCİ EN HIZLI HANGİ BÖLGELERDE ARTTI?
DSÖ’nün çalışmasına göre, antibiyotik direncinin en hızlı arttığı yerler ise Güneydoğu Asya ve Doğu Akdeniz bölgeleri oldu; burada bildirilen her üç bakteriyel enfeksiyondan yaklaşık biri temel antibiyotiklere direniyor. Afrika'nın bazı bölgelerinde ise enfeksiyonların beşte biri dirençli ve sağlık hizmetleri tanı ile tedavide zorlanıyor.
En tehlikeli tehditlerden biri, birçok antibiyotiğe direnç sağlayan ekstra koruyucu dış zara sahip Gram-negatif bakteriler. Escherichia coli ve Klebsiella pneumoniae gibi bakteriler, sepsis ve organ yetmezliğine yol açarak kan dolaşımı enfeksiyonlarındaki dirençli vakaların büyük kısmını oluşturuyor ve bu enfeksiyonlarda ilaç direnci yüzde 40’ı aşıyor. Ayrıca, doktorların uzun süredir son çare olarak kullandığı güçlü karbapenem antibiyotiklerine karşı da direnç artıyor. Karbapenem direncinin yükselmesi, kritik enfeksiyonlarda hayati tedavileri etkisiz hale getiriyor ve doktorları, daha uzun yatış ve yakından takip gerektiren, eski ve daha toksik antibiyotiklere yönelmeye zorluyor.
ÖLÜMLER HIV VE SITMAYI GERİDE BIRAKTI
Öte yandan, DSÖ’nün çalışması antibiyotik dirençli enfeksiyonlardan kaynaklanan ölümlerin tahmin edilenden çok daha yüksek olduğunu gösterdi. 2019 yılında yapılan bir araştırmaya göre, doğrudan antibiyotik dirençli bakteriyel enfeksiyonlardan kaynaklanan ölümlerin 1,27 milyon olduğu ve dirençle ilişkili ölümlerin ise 4,95 milyona ulaştığı tahmin edildi. Bu rakamlar ise dirençli enfeksiyonların her yıl HIV veya sıtmadan daha fazla insanı öldürdüğü anlamına geliyor.
Antibiyotik direncine doğrudan atfedilebilen ölümlerin 2050 yılına kadar ise her yıl yaklaşık 1,91 milyon civarında olacağı tahmin ediliyor. Bu, 2022'ye kıyasla antimikrobiyal dirence bağlı ölümlerde yüzde 70'lik bir artış demek.

YOKSULLUK ANTİYOBİTİK DİRENCİNDE ARTIŞA NEDEN OLUYOR
Dünya genelindeki ülkelerin yaklaşık yarısı hala güvenilir ulusal antimikrobiyal direnç gözetimine sahip değil. Güvenilir yerel verilerin yokluğu, doktorları genellikle antibiyotikleri "her ihtimale karşı" reçete etmeye itiyor; bu da hayat kurtarsa da direnci daha da artırıyor.
Birleşmiş Milletler üyeleri, ölümleri azaltmak ve antibiyotiklere erişimi 2030'a kadar iyileştirmek için siyasi bir deklarasyonu onayladı. Bu anlaşma, insan, hayvan ve çevre sağlığını birbirine bağlayan "Tek Sağlık" yaklaşımını güçlendirmeyi, test ve aşılara erişimi genişletmeyi, gereksiz antibiyotik kullanımını azaltmayı ve yeni tedaviler için araştırmaları desteklemeyi taahhüt ediyor.
ANTİBİYOTİK DİRENCİ MODERN TIPTAN DAHA HIZLI İLERLİYOR
Dünya Sağlık Örgütü (DSÖ) Direktörü Tedros Adhanom Ghebreyesus, antibiyotik direncinin modern tıptan daha hızlı ilerlediği uyarısında bulunarak, bu eğilimi yavaşlatmak için hastanelerde el hijyeni, aşılama programları, temiz içme suyu ve kanalizasyon gibi temel halk sağlığı önlemlerinin kritik önem taşıdığını vurguladı.






